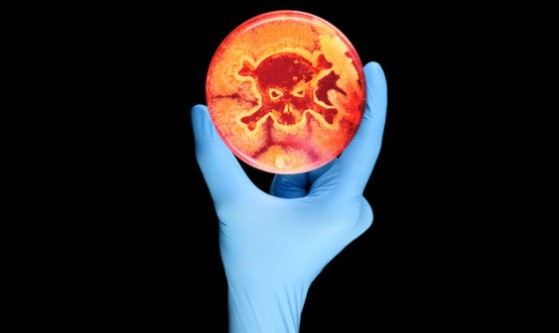

Shiga toxin-producing E. coli (STEC) and Listeria infections in Europe are at their highest levels since the start of EU-wide surveillance in 2007.
Data comes from two 2023 epidemiological reports issued recently by the European Centre for Disease Prevention and Control (ECDC), which cover the European Union and European Economic Area (EEA).
Click Here For More Information
Europe
© Prepping Communities. This content is for informational purposes only and not professional advice. Use at your own risk.
Terms | Privacy | Guidelines